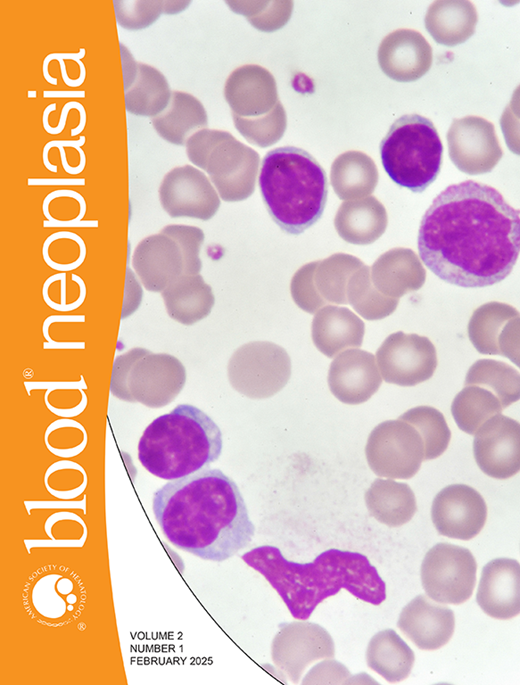

TO THE EDITOR:
Bruton tyrosine kinase (BTK) inhibitors (BTKis) have transformed the treatment landscape of chronic lymphocytic leukemia (CLL)/small lymphocytic lymphoma, the most prevalent form of leukemia in adults.1 However, the clinical benefit of ibrutinib is accompanied by several side effects and treatment-related toxicities.2,3
Acalabrutinib, approved for use in CLL in 2019, is a second-generation irreversible BTKi with greater selectivity for BTK than ibrutinib. The ELEVATE-RR trial compared treatment with ibrutinib vs acalabrutinib in previously treated CLL, showing similar progression-free survival with both agents, but fewer adverse events (AEs) were seen in patients treated with acalabrutinib.4 Both ibrutinib and acalabrutinib have become standards of care in CLL due to their survival benefits compared with chemoimmunotherapy.
Continuous treatment with BTKi is required to maintain clinical benefit; however, side effects can become a limiting factor for successful long-term use. Fatigue, rash, diarrhea, bleeding and bruising, neutropenia, arrhythmias, infections, and hypertension have been linked to BTKi treatment.5-9
Although the efficacy and toxicity of ibrutinib and acalabrutinib have been well described in clinical trials, it is important to determine how they compare in the real world, particularly when patients are treated for an extended period of time. One recent real-world study comparing acalabrutinib and ibrutinib treatment in patients with CLL showed lower rates of discontinuation and a longer time to discontinuation than ibrutinib,10 whereas a separate study using the Acentrus database showed that patients treated with acalabrutinib were 89% more likely to start a new treatment than those treated with ibrutinib.11 To further investigate these potential discrepancies, we used TriNetX, a federated electronic medical record network,12 to examine the safety profile in patients treated for CLL with either ibrutinib or acalabrutinib for at least 1 year.
The data used in this study were collected on 17 September 2024 from the TriNetX US Collaborative Network (with natural language processing), which provided access to electronic medical records (diagnoses, procedures, medications, laboratory values, and genomic information) from ∼115 million patients across 66 health care organizations.
International Classification of Diseases, Tenth Revision, Clinical Modification (ICD-10-CM), International Classification of Diseases for Oncology, Third Edition (ICD-O-3) (supplemental Table 1), and the Standardized nomenclature for clinical drugs for humans (National Library of Medicine) (RxNorm) codes were used to define the study population based on medical diagnoses and prescribed drugs, respectively. Patients with a diagnosis of either CLL of B-cell type or small cell B-cell lymphoma who had a prescription for treatment with either ibrutinib or acalabrutinib for at least 1 year were included in the analysis. Patients who were treated with alternative BTKis were excluded from each group.
Using the TriNetX platform, we performed propensity score matching (PSM) to control for baseline differences between cohorts on age at the initiation of therapy, race and ethnicity, history of treatment with venetoclax, rituximab, and obinutuzumab (within past 1 year), and comorbidities that may affect the risk of AEs (diabetes mellitus, obesity, and history of atrial fibrillation). After optimization of the 2 cohorts, AEs and outcomes were identified and counted with ICD-10-CM codes from the onset of treatment to the date of the study cutoff.
Statistical analysis was performed on the TriNetX platform using the Advance Analytics “Compare Outcomes” tool. The analysis used the initiation of treatment with the respective BTKi as the index event. The TriNetX platform identifies AEs when the diagnoses are reported to occur after the index event. The hazard ratio for the development of AEs occurring from the start of BTKi therapy, comparing patients treated with ibrutinib vs patients treated with acalabrutinib, was analyzed using the TriNetX platform. Kaplan-Meier curves were generated, and survival distribution was compared using log-rank test. Χ2 test for proportionality was used to identify analysis that fulfilled the proportionality assumption of the analysis. Log-rank tests that showed significant differences between the 2 treatment arms were identified. Data of patients who did not develop specific AEs were censored at the last date of known clinical activity.
A total of 120 618 adult patients with CLL in the United States were identified from the database during the period. Among these, 2979 were treated with ibrutinib, and 958 were on acalabrutinib therapy. After PSM, there were 944 patients in each arm of the study (supplemental Figure 1). We compared outcomes between patients who were treated continuously with ibrutinib or acalabrutinib for 12 months at least, to ensure consistent treatment exposure and assess differences in outcome; the window of analysis extended from 22 November 2019 to 17 September 2024. Follow-up for patients lasted 2 years from treatment initiation.
The mean age at treatment initiation was 70.3 years for both cohorts; 58.4% of ibrutinib and 58.6% of acalabrutinib patients were males. A complete report of demographics, along with baseline comorbidities, is provided in Table 1. All-cause mortality was significantly higher among patients treated for at least 12 months with ibrutinib than patients treated for at least 12 months with acalabrutinib. These patients were also at increased risk of hemorrhage, essential hypertension, urinary tract infections, cellulitis, and muscle spasms. Headache and acute upper respiratory tract infections were more common in patients treated with acalabrutinib than with ibrutinib. Strikingly, more Richter transformations were reported among the ibrutinib cohort than the acalabrutinib cohort.
The results of our study suggest that acalabrutinib may have a more favorable AE profile than ibrutinib, which corroborates the findings from prospective trials and similar retrospective studies with smaller patient populations.10,13
We observed atrial fibrillation/flutter were slightly more common in patients treated with ibrutinib, but the difference did not reach statistical significance.4,13 Because atrial fibrillation/flutter is known to be a late complication, it is possible that the detection of differences in this event may require longer follow-up.
Our results concur with large randomized clinical trials on adverse effects of hemorrhage and headache with the treatment types (Table 2).4,13
Consideration of side effect profiles is essential in BTKi treatment selection, especially because high rates of treatment discontinuation due to AEs have been reported with both ibrutinib (12%-50%) and acalabrutinib (22%-47%).10,13 Similarly, AEs are the most common reason for discontinuation with alternate BTKis.14,15 However, differences in study design limit the ability to directly compare results across trials.
There are inherent limitations to this study. TriNetX uses electronic medical record data, which are primarily maintained for patient care rather than research. No cytogenetic characteristics of CLL were known. Due to the retrospective nature of our analysis, there may be important differences in patient characteristics between the cohorts. PSM was used to balance groups based on baseline characteristics, although confounding variables may persist and affect our results.
In this large, real-world comparison of the efficacy and safety profiles of acalabrutinib and ibrutinib, we illustrate the potential benefits of acalabrutinib compared with ibrutinib for both overall survival and reduced key AEs. These real-world data could aid providers when considering which medication regimens to use to improve both patient outcomes and their likelihood of better tolerating their treatment. A large, long-term cohort study may be useful to validate these findings.
Contribution: R.H., F.I., T.Z.R., M.P., A.F., A.S.K., M.L., and P.P. contributed to study design; R.H., F.I., A.S.K., M.P., and M.L. contributed to data analysis and interpretation; and all authors contributed to writing and editing this article.
Conflict-of-interest disclosure: The authors declare no competing financial interests.
Correspondence: Ramsay Hafer, 21 Longknoll Way, Kingsville, MD 21087; email: rah151@jefferson.edu; and Pierluigi Porcu, Division of Hematologic Malignancies and Hematopoietic Stem Cell Transplantation, Department of Medical Oncology, Thomas Jefferson University, 834 Chestnut St, Suite 320, Philadelphia, PA 19017; email: pierluigi.porcu@jefferson.edu.
References
Author notes
Data supporting the findings of this study are available from the TriNetX Analytics Network (https://trinetx.com).
The full-text version of this article contains a data supplement.